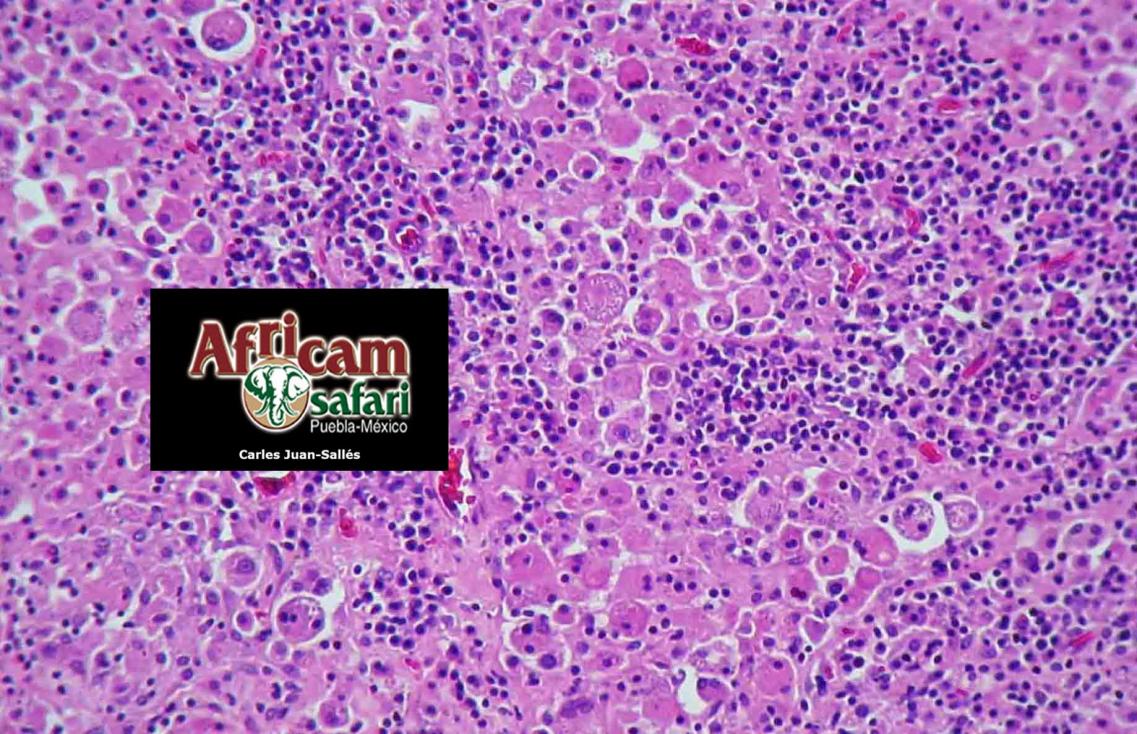

Enfermedades de una colonia de maras (Dolichotis patagonum)
Realización de estudios sobre causas de morbilidad y mortalidad en especies con escasa documentación bibliográfica médica pero mantenidas frecuentemente en cautividad como las liebres de la Patagonia. Publicaciones:
1- Pathological findings in a captive colony of maras (Dolichotis patagonum). Veterinary Record 158:727-31, 2006
2- Disseminated Histoplasma capsulatum var. capsulatum in a captive mara (Dolichotis patagonum). Veterinary Record 155:426-8, 2004
3- Pulmonary besnoitiasis in captive maras (Dolichotis patagonum) associated with interstitial pneumonia.” Veterinary Pathology 41:408-11, 2004
4- Second case of histoplasmosis in a captive mara (Dolichotis patagonum): pathological findings. Mycopathologia 168:95-100, 2009
5- Identification of the source of histoplasmosis infection in two captive maras (Dolichotis patagonum) from the same colony using molecular and immunologic assays. Revista Argentina de Microbiología 41:102-4, 2009
6- Pulmonary arterial disease associated with right-sided cardiac hypertrophy and congestive heart failure in zoo mammals housed at 2,100 m above sea level. Journal of Zoo and Wildlife Diseases 46(4):825-32, 2015